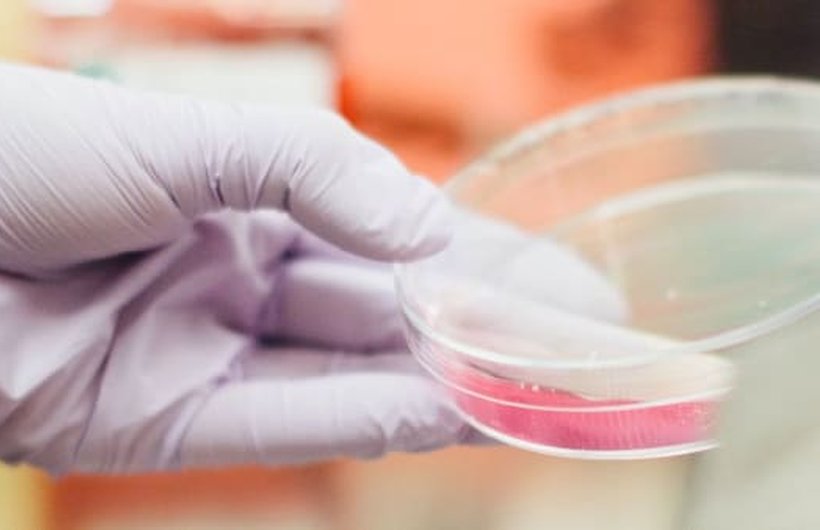

BEACON study opens in Europe
Solving Kids’ Cancer is delighted to announce that the much-anticipated BEACON study amendment to trial the anti-GD2 monoclonal antibody therapy Qarziba™ in combination with chemotherapy for children with relapsed or refractory neuroblastoma is now open and recruiting patients in Europe.
This new clinical trial will be available to children in 40 hospitals across 11 European countries and has been jointly funded by Solving Kids’ Cancer (Europe) and the French charity, Imagine for Margo.
It is sponsored by the Clinical Trials Unit at the University of Birmingham and conducted via the Innovative Therapies for Children with Cancer (ITCC) network.
Success in North America
Successful studies in North America conducted by the Children’s Oncology Group have combined Unituxin™ with chemotherapy, which has led to the combination becoming firstline standard of care for patients with relapsed or refractory neuroblastoma.
Dr Lucas Moreno, Lead Investigator on the BEACON study and Clinical Director at Vall D’Hebron, Barcelona, said: “We are delighted that the BEACON Immuno trial has now started recruitment across Europe.”
“This trial brings hope for patients and families with relapsed and refractory neuroblastoma. The combination of chemotherapy with anti-GD2 immunotherapy has shown great promise in trials in the US and is now available in Europe within a clinical trial. We are enormously grateful to Imagine for Margo and Solving Kids’ Cancer for their support to the study. This treatment would not be available today without their engagement, help and support.

“We hope that the trial will recruit rapidly and provide us with robust data on this new treatment regimen within two years, so that more patients can benefit from it, if it proves successful.”
Dr Lucas Moreno
Maximising benefit for children in clinical trials
As part of the BEACON study children will be randomised to receive either chemotherapy plus Qarziba™ or chemotherapy alone. But the trial has two important aspects to maximise potential patient benefit.
Firstly, out of every three patients, two will be randomised to receive chemotherapy plus Qarziba™ and only one child will receive chemotherapy alone. Secondly, if a child who receives chemotherapy alone experiences progression of their disease within 30 months of entering the trial, they will automatically become eligible to receive chemotherapy plus Qarziba™ at that point.
Together this means that every child will have the opportunity to receive this new combination therapy as either a first or second relapse therapy.
“We know how vital it is that clinical trials maximise potential benefit for children right now, but we must also appreciate the needs of future children. This trial has the potential to go on to become the new standard of care for treating such children in the future.
A study that only has the potential to benefit children who happen to be able to participate in it is not going to lead to more effective treatments in the future. Alongside maximising patient benefit we have to ensure that studies are scientifically robust such that improvements lead to licensing and drug approval. In the future clinicians can then prescribe such treatments as standard.”
Nick Bird, Chair of Trustees

Imagine for Margo
Patricia Blanc, Founder and President of Imagine for Margo, said: “Imagine for Margo‘s ambition is to accelerate access to innovative therapies for children and adolescents with cancer in Europe. Cure better and cure more all types of cancer is our priority. Neuroblastoma being a specific paediatric disease, and still very aggressive at relapse, it is important for us to finance the best possible treatment and to give hope to those children and their families.”
Chemotherapy and anti-GD2 Monoclonal Antibody Therapy - “Chemoimmunotherapy”
There is emerging evidence of the benefit of the combination of anti-GD2 therapy with chemotherapy (so called “chemoimmunotherapy”). In the Children’s Oncology Group ANBL1221 trial, a total of 53 eligible patients were assigned to receive chemotherapy plus dinutuximab and GM-CSF, 22 with relapsed disease and 31 with refractory/progressive disease. Of the 53 patients, 21 (40%) experienced objective responses (11 Complete Remission, ten Partial Remission), seven had progression and 23 stable disease. Two patients did not receive protocol therapy (Mody 2018).
This compares to results as reported at ASCO earlier this year in the original BEACON study where 61 patients were randomized to treatment with Temozolomide alone (T) and 60 to Temozolomide and Irinotecan (TI) - a total of 66 with relapsed disease and 55 with refractory disease. The objective response rate was 24% for T and 17% for IT (Moreno 2019).
Another anti-GD2 antibody – hu14.18K322A – combined with induction chemotherapy potentially shows benefit when used upfront in newly diagnosed patients. In a single-institution non-randomised study conducted at St. Jude, response rates of 76% were seen, higher than the 40% seen in historical controls (Federico 2017).
Research Funding
Since its creation at the end of 2011, Imagine for Margo has allocated more than €7,000,000 to finance 12 French and European research programs in order to accelerate the research against childhood cancer. These research programs have been financed thanks by the hugely successful Children without Cancer races since 2012.
Solving Kids’ Cancer acknowledges all those children whose funds enable us to drive forward our research work in pursuit of more effective treatments to help children with neuroblastoma both now and in the future, and extends its sincere gratitude to families for their ongoing support. We particularly remember those children who are very sadly no longer with us, our work and our steadfast commitment to research in order to find more effective treatments for children with neuroblastoma honours all their memories.